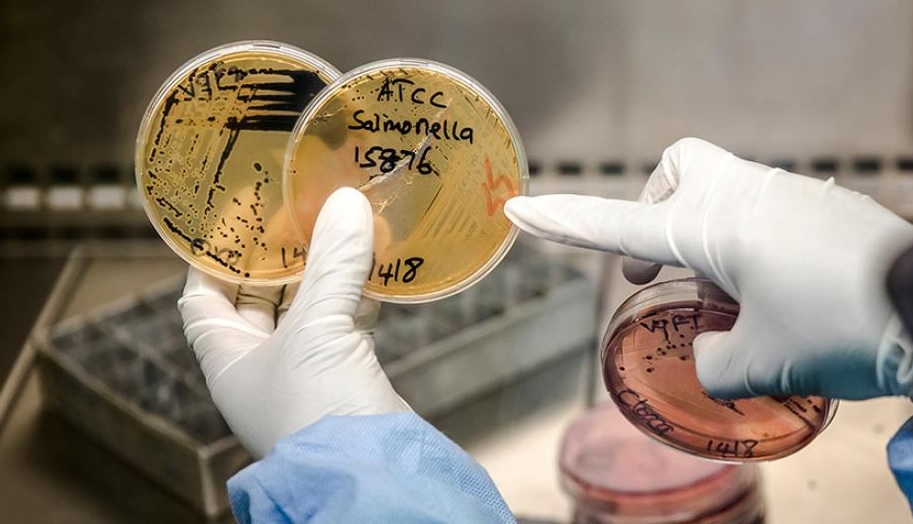

Mundo
miércoles 07 de julio de 2021
Agenda especial para los Días de la Ciencia (del 8 al 9 de julio)
Foto: Naciones Unidas
La ciencia, la tecnología y la innovación son fundamentales para la transformación de los sistemas alimentarios, desde alimentos seguros hasta dietas saludables o el incremento de la productividad agrícola
Esta noticia la leyeron 30623 personas
Los Días de la Ciencia (del 8 al 9 de julio), organizados por la Cumbre sobre los Sistemas Alimentarios de las Naciones Unidas y la FAO, ofrecen la oportunidad de evaluar opciones basadas en la ciencia, explorar las fronteras de la misma, evaluar sus riesgos, oportunidades y controversias o fortalecer la política basada en la ciencia.
Únete a nosotros para contribuir al debate científico sobre cómo transformar nuestros sistemas alimentarios y compartir experiencias y conocimientos sobre acciones y soluciones basadas en la ciencia.
Reconociendo el papel fundamental de la ciencia, la tecnología y la innovación para la transformación de los sistemas alimentarios, los Días de la ciencia, organizados por el Grupo Científico de la Cumbre de Sistemas Alimentarios de las Naciones Unidas y facilitados y hospedados por la FAO, ofrecen una importante oportunidad para apoyar el proceso de establecimiento de la agenda con evidencia científica. y perspectivas.
Los participantes pueden esperar:
> Evaluar opciones basadas en la ciencia para lograr dietas más saludables y sistemas alimentarios más eficientes, inclusivos, resilientes y sostenibles.
> Explorar las fronteras de la ciencia para catalizar la transformación de los sistemas alimentarios para lograr el ODS2.
> Evaluar críticamente los riesgos, las oportunidades y las controversias en ciencia e innovación para los sistemas alimentarios, prestando atención a la equidad y la resiliencia.
> Participar en diálogos para fortalecer la interfaz ciencia-política para que la evidencia científica pueda informar mejor las políticas y las políticas, a su vez, puedan utilizar mejor la ciencia para apoyar la transición hacia sistemas alimentarios sostenibles, inclusivos y resilientes.
Fuente: Boyacá Radio PRENSA -Cecilia- con información de Naciones Unidas
Esta noticia la leyeron 30623 personas
Noticias Relacionadas
Lo más visto en BR

Últimas Noticias
Conoce el sistema radial Online del Grupo Red Andina Radio & TV. Donde sus selectos oyentes y visitantes pueden complacer su oido con las mejores notas músicales con un variado listado de emisoras























.jpeg)


